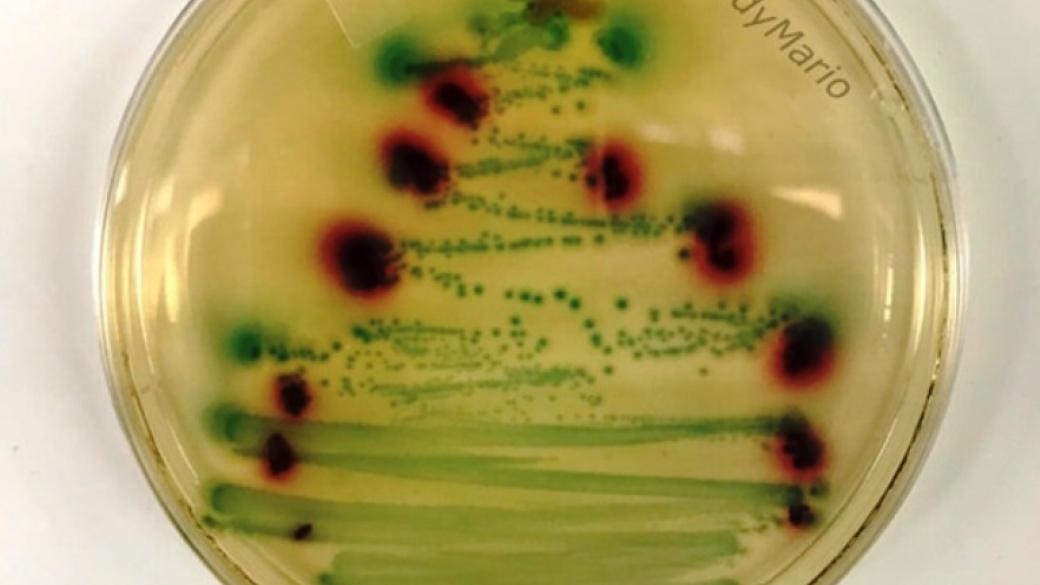

Пользователи сети опубликовали яркие фото со своими новогодними елками, часть из которых отличаются незаурядной креативностью и фантазией.
Судя по фото, люди с хорошим чувством юмора попытались создать новогоднее настроение даже во время работы и поделились своими креативными идеями на страницах в социальных сетях.
Фото







Новости по теме

В сети появилось забавное видео, как лебедь в парке научил девушку правильно носить маску
В сети появилось забавное видео, как лебедь в парке научил девушку правильно носить маску

В сети показали архивные снимки пандемии испанского гриппа
В сети показали архивные снимки пандемии испанского гриппа

В сети публикуют уникальные фото кольцевого солнечного затмения
В сети публикуют уникальные фото кольцевого солнечного затмения